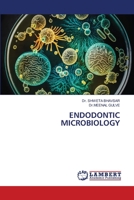
Endodontic Microbiology 6207841735 Book Cover

- Parodontite apicale des dents obturées (French Edition)
- Parodontite apicale nei denti otturati (Italian Edition)
- Apikale Parodontitis bei obturierten Zähnen (German Edition)
- Periodontite apical em dentes obturados (Portuguese Edition)
- Determinação do comprimento de trabalho em endodontia (Portuguese Edition)